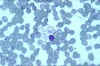

Comparison of different methods for delayed post-mortem diagnosis of falciparum malaria
- PMID: 19863789
- PMCID: PMC2774866
- DOI: 10.1186/1475-2875-8-244
Comparison of different methods for delayed post-mortem diagnosis of falciparum malaria
Abstract
Background: Between 10,000 and 12,000 cases of imported malaria are notified in the European Union each year. Despite an excellent health care system, fatalities do occur. In case of advanced autolysis, the post-mortem diagnostic is impaired. Quicker diagnosis could be achieved by using rapid diagnostic malaria tests.
Methods: In order to evaluate different methods for the post-mortem diagnosis of Plasmodium falciparum malaria in non-immunes, a study was performed on the basis of forensic autopsies of corpses examined at variable intervals after death in five cases of fatal malaria (with an interval of four hours to five days), and in 20 cases of deaths unrelated to malaria. Detection of parasite DNA by PCR and an immunochromatographic test (ICT) based upon the detection of P. falciparum histidine-rich protein 2 (PfHRP2) were compared with the results of microscopic examination of smears from cadaveric blood, histopathological findings, and autopsy results.
Results: In all cases of fatal malaria, post-mortem findings were unsuspicious for the final diagnosis, and autoptic investigations, including histopathology, were only performed because of additional information by police officers and neighbours. Macroscopic findings during autopsy were unspecific. Histopathology confirmed sequestration of erythrocytes and pigment in macrophages in most organs in four patients (not evaluable in one patient due to autolysis). Microscopy of cadaveric blood smears revealed remnants of intraerythrocytic parasites, and was compromised or impossible due to autolysis in two cases. PCR and ICT performed with cadaveric blood were positive in all malaria patients and negative in all controls.
Conclusion: In non-immune fatalities with unclear anamnesis, ICT can be recommended as a sensitive and specific tool for post-mortem malaria diagnosis, which is easier and faster than microscopy, and also applicable when microscopic examination is impossible due to autolysis. PCR is more expensive and time-consuming, but may be used as confirmatory test. In highly endemic areas where asymptomatic parasitaemia is common, confirmation of the diagnosis of malaria as the cause of death has to rely on histopathological findings.
Figures

References
-
- WHO World Malaria Report 2008 http://www.who.int/malaria/wmr2008
-
- WHO Malaria in the WHO European region, current malaria trends: imported malaria, last update Feb 2007 http://www.euro.who.int/malaria/ctryinfo/ctryinfotop
Publication types
MeSH terms
Substances
LinkOut - more resources
Full Text Sources